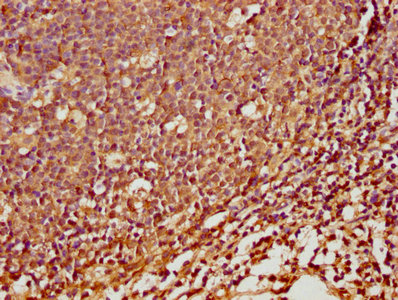

SPINK5 Antibody
-
中文名稱:SPINK5兔多克隆抗體
-
貨號(hào):CSB-PA889077LA01HU
-
規(guī)格:¥440
-
圖片:
-
IHC image of CSB-PA889077LA01HU diluted at 1:100 and staining in paraffin-embedded human cervical cancer performed on a Leica BondTM system. After dewaxing and hydration, antigen retrieval was mediated by high pressure in a citrate buffer (pH 6.0). Section was blocked with 10% normal goat serum 30min at RT. Then primary antibody (1% BSA) was incubated at 4°C overnight. The primary is detected by a biotinylated secondary antibody and visualized using an HRP conjugated SP system.
-
IHC image of CSB-PA889077LA01HU diluted at 1:100 and staining in paraffin-embedded human tonsil tissue performed on a Leica BondTM system. After dewaxing and hydration, antigen retrieval was mediated by high pressure in a citrate buffer (pH 6.0). Section was blocked with 10% normal goat serum 30min at RT. Then primary antibody (1% BSA) was incubated at 4°C overnight. The primary is detected by a biotinylated secondary antibody and visualized using an HRP conjugated SP system.
-
-
其他:
產(chǎn)品詳情
-
產(chǎn)品名稱:Rabbit anti-Homo sapiens (Human) SPINK5 Polyclonal antibody
-
Uniprot No.:
-
基因名:
-
別名:Hemofiltrate peptide HF7665 antibody; ISK5_HUMAN antibody; LEKTI antibody; Lympho-epithelial Kazal-type-related inhibitor antibody; Lymphoepithelial Kazal type related inhibitor antibody; NETS antibody; NS antibody; Serine peptidase inhibitor Kazal type 5 antibody; SPINK5 antibody; VAKTI antibody
-
宿主:Rabbit
-
反應(yīng)種屬:Human
-
免疫原:Recombinant Human Serine protease inhibitor Kazal-type 5 protein (722-847AA)
-
免疫原種屬:Homo sapiens (Human)
-
標(biāo)記方式:Non-conjugated
本頁(yè)面中的產(chǎn)品,SPINK5 Antibody (CSB-PA889077LA01HU),的標(biāo)記方式是Non-conjugated。對(duì)于SPINK5 Antibody,我們還提供其他標(biāo)記。見(jiàn)下表:
-
克隆類型:Polyclonal
-
抗體亞型:IgG
-
純化方式:>95%, Protein G purified
-
濃度:It differs from different batches. Please contact us to confirm it.
-
保存緩沖液:Preservative: 0.03% Proclin 300
Constituents: 50% Glycerol, 0.01M PBS, pH 7.4 -
產(chǎn)品提供形式:Liquid
-
應(yīng)用范圍:ELISA, IHC
-
推薦稀釋比:
Application Recommended Dilution IHC 1:20-1:200 -
Protocols:
-
儲(chǔ)存條件:Upon receipt, store at -20°C or -80°C. Avoid repeated freeze.
-
貨期:Basically, we can dispatch the products out in 1-3 working days after receiving your orders. Delivery time maybe differs from different purchasing way or location, please kindly consult your local distributors for specific delivery time.
-
用途:For Research Use Only. Not for use in diagnostic or therapeutic procedures.
相關(guān)產(chǎn)品
靶點(diǎn)詳情
-
功能:Serine protease inhibitor, probably important for the anti-inflammatory and/or antimicrobial protection of mucous epithelia. Contribute to the integrity and protective barrier function of the skin by regulating the activity of defense-activating and desquamation-involved proteases. Inhibits KLK5, it's major target, in a pH-dependent manner. Inhibits KLK7, KLK14 CASP14, and trypsin.
-
基因功能參考文獻(xiàn):
- SPINK5 gene R654H might be a risk factor for epidermal barrier dysfunction in some Japanese AD patients. PMID: 29926005
- Early-onset atopic dermatitis was associated with rs2303067 in SPINK5, which is involved in skin barrier functioning, and late-onset was associated with rs4950928 in CHI3L1, which is involved in the immune response. Future studies should examine the early- versus late-onset subgrouping more closely PMID: 28681574
- report, for the first time, association between SPINK5 variant rs9325071 and challenge-proven IgE-mediated food allegy PMID: 28213955
- impaired KLK7 secretion from lamellar granules and increased LEKTI expression could underlie the insufficient activation of KLK in atopic dermatitis. PMID: 27769847
- This report discloses a prevalent SPINK5 founder mutation in Finland and illustrates Netherton syndrome phenotype variability PMID: 26865388
- New mutation leading to the full variety of typical features of the Netherton syndrome. PMID: 26031502
- The results suggest that SPINK5 and ADRB2 haplotypes might play a role in the susceptibility to childhood-onset asthma PMID: 25233048
- The effect of GATA3 on SPINK5 expression was indirect and GATA3 alone was insufficient for final differentiation of keratinocytes where full SPINK5 expression was observed. PMID: 24894987
- these results support epistasis between SPINK5 and TSLP, which contributes to childhood asthma. PMID: 24831437
- Netherton syndrome is caused by mutations in SPINK5, which encodes the serine protease inhibitor LEKTI. PMID: 24577329
- Herein we report three patients with Netherton syndrome who had growth retardation associated with GH deficiency and responded well to GH therapy. PMID: 24015757
- mesotrypsin contributes to the desquamation process by activating KLKs and degrading the intrinsic KLKs' inhibitor LEKTI PMID: 24390132
- The E420K LEKTI variant alters LEKTI proteolytic activation and results in protease deregulation. PMID: 22730493
- major binding partners of LEKTI were found to be the antimicrobial peptide dermcidin and the serine protease cathepsin G and no kallikreins. PMID: 22588119
- Our study represents the first identification of a Netherton disease-causing SPINK5 mutation that alters splicing without affecting canonical splice sites. PMID: 22377713
- the SPINK5 gene polymorphisms was found not to be associated with atopic dermatitis (AD) in regard to either serum IgE levels, concurrent allergic asthma or early onset of AD PMID: 21585560
- Lowered SPINK5 protein expression might be a contributing factor for the development of chronic rhinosinusitis. PMID: 22570283
- Distinct SPINK5 and IL-31 gene variants (SNPs) were associated with the development of atopic eczema and non-atopic hand dermatitis in Taiwanese nurses. PMID: 22017185
- New SPINK5 defects in 12 patients, who presented a clinical triad suggestive of Netherton syndrome with variations in inter- and intra-familial disease expression were disclosed. PMID: 22089833
- The novel mutation, p.Gln333X, in the SPINK5 gene, is responsible for a mild Netherton syndrome phenotype in a Turkish pedigree. PMID: 21564178
- Six SNPs (rs17718511, rs17860502, KN0001820, rs60978485, rs17718737, and rs1422985) and the haplotype TAA (rs60978485, rs6892205, rs2303064) in the SPINK5 gene were associated with atopic dermatitis in Koreans. PMID: 21087323
- Caspase 14 has been implicated as a novel target of LEKTI, which has the potential to act as both a serine and a cysteine protease inhibitor. PMID: 20533828
- study reports two male siblings affected by Netherton syndrome, which resulted from a previously undescribed splicing mutation in SPINK5 PMID: 20107740
- Highly significant associations were detected between SPINK5 single nucleotide polymorphisms and visible eczema (but not IgE levels) and between IL13 variants and total IgE. PMID: 20085599
- Even though the number of investigated subjects was small and hydrolytic activity was only slightly increased, the results denote that LEKTI might be diminished in atopic dermatitis PMID: 19522716
- SPINK5's role in atopic dermatitis and skin diseases is described PMID: 11796258
- the intron-exon organization of the gene and characterize the spink5 mutations. five mutations, one of which resulted in perinatal lethal disease, were associated with ethnic groups PMID: 11841556
- the defective inhibitory regulation of desquamation due to SPINK5 gene mutations may cause over-desquamation of corneocytes in Netherton syndrome, leading to severe skin permeability barrier dysfunction. PMID: 11874482
- This is a multidomain serine proteinase inhibitor with physiopathological significance. PMID: 11943586
- REVIEW: molecular cloning, characterization of the gene, tissue distribution, congenital disases associated with mutations PMID: 12437098
- LETKI proteolytic processing was studied in cultured keratinocytes as well as its tissue distribution and defective expression in Netherton syndrome. PMID: 12915442
- There is an association between polymorphisms in the SPINK5 gene and atopic dermatitis in the Japanese. PMID: 14551605
- LEKTI deficiency in the epidermis and in hair roots at the protein level and an aberrant expression of other proteins, especially transglutaminase1 and 3, which may account for the impaired epidermal barrier in Netherton syndrome PMID: 15304086
- The sequence from Leu32 to Ile38 of a chimeric double-mutant domain 1 of LEKTI is a chameleon sequence that converts a short 3(10)-helix into an extended loop conformation and parts of the COOH-terminal alpha-helix of domain 1 into a beta-hairpin. PMID: 15366933
- deficiency is related to epidermal detachment, desmosomal dissociation, and destabilization of corneodesmosin PMID: 15466487
- in normal skin the LG system transports and secretes LEKTI earlier than KLK7 and KLK5 preventing premature loss of stratum corneum integrity/cohesion. PMID: 15675955
- We showed that LEKTI is a potent inhibitor of a family of serine proteinases involved in extracellular matrix remodeling and its expression is downregulated in head and neck squamous cell carcinomas. PMID: 15680911
- Homozygous frameshift mutation in SPINK5 associated with Netherton syndrome. PMID: 15942217
- Variable amounts of SPINK5 alternative transcripts are detected in all SPINK5 transcriptionally active tissues. PMID: 16374478
- Mutations in SPINK5 encoding the serine protease (SP) inhibitor, lymphoepithelial-Kazal-type 5 inhibitor (LEKTI), cause Netherton syndrome (NS). SP activation correlated with clinical severity, and inversely with residual LEKTI expression. PMID: 16601670
- Uniparental disomy of maternal SPINK5 allele was indicated in the mutation analysis of two Taiwanese patients with Netherton syndrome. PMID: 17415575
- These results identify KLK5, a key actor of the desquamation process, as the major target of LEKTI. PMID: 17596512
- LEKTI domain 15 is a functional Kazal-type proteinase inhibitor. PMID: 17936012
- SPINK5 mutations, causing NS, lead to truncated LEKTI; each Netherton syndrome patient possesses LEKTI of a different length, depending on the location of mutations PMID: 17989726
- study in children and adults with atopic dermatitis found that an association with SPINK5 E420K SNP was not confirmed. However, this was associated with high IgE serum levels (p=0.011). PMID: 17989887
- SPINK5 (LEKTI) protein was detected in sinonasal tissue and was significantly decreased in polyp samples using IHC. PMID: 18588753
- SPINK5 mutation confers a risk of eczema when maternally inherited but is not a major eczema risk factor; no interaction between the SPINK5 risk allele or the putative KLK7 risk allele and FLG mutations ws found PMID: 18774391
- reduced expression of LEKTI and increased expression of SCCE and SCTE in human epidermal keratinocytes after UVB irradiation may contribute to desquamation of the stratum corneum. PMID: 19118981
- Haploinsufficiency of SPINK5 can cause the Netherton syndrome phenotype in the presence of one null mutation with homozygous G1258A polymorphisms in SPINK5, and this could impair the function of LEKTI and therefore acts as a true mutation. PMID: 19438860
- -206G>A polymorphism in the SPINK5 is associated with asthma susceptibility in a Chinese Han population PMID: 19534795
顯示更多
收起更多
-
相關(guān)疾病:Netherton syndrome (NETH)
-
亞細(xì)胞定位:Secreted.
-
組織特異性:Highly expressed in the thymus and stratum corneum. Also found in the oral mucosa, parathyroid gland, Bartholin's glands, tonsils, and vaginal epithelium. Very low levels are detected in lung, kidney, and prostate.
-
數(shù)據(jù)庫(kù)鏈接:
Most popular with customers
-
YWHAB Recombinant Monoclonal Antibody
Applications: ELISA, WB, IHC, IF, FC
Species Reactivity: Human, Mouse, Rat
-
Phospho-YAP1 (S127) Recombinant Monoclonal Antibody
Applications: ELISA, WB, IHC
Species Reactivity: Human
-
-
-
-
-
-